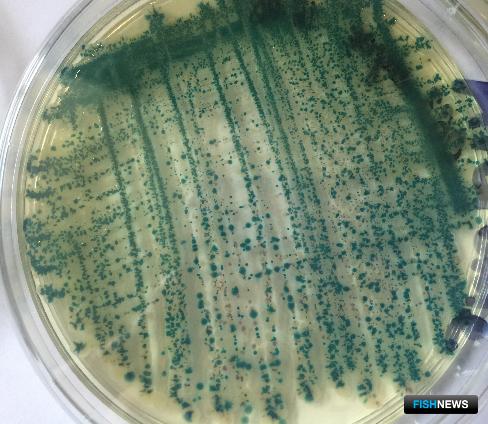
Ученые продолжат наблюдение за здоровьем крымских устриц

Рыбные новости – новости рыбной индустрии на Fish25.Ru
- Подробности
-
Опубликовано 06.09.2019 12:00

В ходе мониторинга устрично-мидийных хозяйств Крыма и черноморского побережья Кавказа специалисты АзНИИРХ взяли пробы для оценки состояния моллюсков.Также образцы проверят на потенциально опасные для этих животных патогены.
Специалисты Азово-Черноморского филиала ВНИРО (АзНИИРХ) завершили очередной этап мониторинга устрично-мидийных хозяйств, расположенных в Крыму и на черноморском побережье Кавказа. Во время комплексных обследований рабочая группа института отобрала материал для диагностики физиологического, паразитологического и микробиологического состояния устриц в летний период.
В каждом хозяйстве ученые уточняли особенности биотехнологии выращивания устриц, происхождение посадочного материала и состояние популяций, рассказали Fishnews в пресс-службе АзНИИРХ. Взятые в экспедиции пробы сотрудники филиала продолжат исследовать в лабораторных условиях для выявления потенциально-опасных патогенов для устриц и уточнения оценки их физиологического статуса.
По результатам диагностики моллюсков марикультурным хозяйствам дадут рекомендации по поддержанию санитарно-эпизоотического благополучия. Специалисты надеются, что исследования также помогут в разработке и усовершенствовании методов диагностики, лечения и профилактики заболеваний устриц, что необходимо для развития марикультуры в Азово-Черноморском бассейне.

Задать вопрос редакцииФИО *Сфера деятельности / предприятие / должность *email *Вопрос *Спасибо, ваш вопрос отправлен в редакцию.
Источник:
fishnews.ru